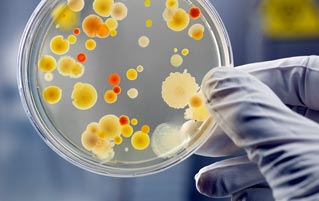
All The Ways Your Microbes Make You YOU

All The Ways Your Microbes Make You YOU
You are a human being. Which means "you" are actually one human plus the trillions of microscopic life forms living in you. And "you" are living in a civilization that's only had microscopes since the 1670s, and only begun to understand what microscopes reveal. And "you" are living on a planet that was dominated by microbial life for about half its natural history, with more complex species only showing up in the last quarter, like a Miami Heat fan in between South Beach clubs. Which all begs the question: is this the microbes' world, and we're just living in it? And what does that mean for us as a species?
On this week's episode of The Cracked Podcast, Alex Schmidt sits down with science journalist Ed Yong (The Atlantic) for a look at the incredible world of microbes we've been living in this whole time, covered brilliantly in Ed's book I Contain Multitudes. Find out how trillions of tiny bacteria & germs guide everything from your nutrition, to our psychology, to the evolution of life on earth itself.
Footnotes:
I Contain Multitudes: The Microbes Within Us and a Grander View of Life by Ed Yong
Stopping the Rise of Superbugs by Making Them Fight For Food (The Atlantic)
40 Years Later, Some Survivors of the First Ebola Outbreak Are Still Immune (The Atlantic)
Brain Cells Share Information With Virus-Like Capsules (The Atlantic)
I Contain Multitudes on YouTube
4 Creepy Things That Secretly Control Your Personality (Cracked)
6 Objective Reasons Why Your Fear of Bacteria Is Irrational (Cracked)
How Your Germs Control Your Politics (with David Wong) (The Cracked Podcast)